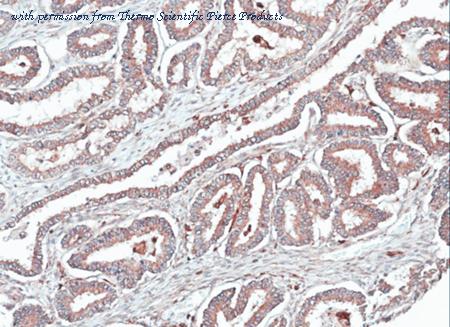

product summary
Loading...
company name :
Invitrogen
other brands :
NeoMarkers, Lab Vision, Endogen, Pierce, BioSource International, Zymed Laboratories, Caltag, Molecular Probes, Research Genetics, Life Technologies, Applied Biosystems, GIBCO BRL, ABgene, Dynal, Affinity BioReagents, Nunc, Invitrogen, NatuTec, Oxoid, Richard-Allan Scientific, Arcturus, Perseptive Biosystems, Proxeon, eBioscience
product type :
antibody
product name :
HOMER1 Polyclonal Antibody
catalog :
PA5-21487
quantity :
100 µL
price :
US 514
clonality :
polyclonal
host :
domestic rabbit
conjugate :
nonconjugated
reactivity :
human, mouse, rat
application :
western blot, immunohistochemistry, immunocytochemistry, immunoprecipitation, immunohistochemistry - paraffin section, immunohistochemistry - frozen section
more info or order :
citations: 2
Published Application/Species/Sample/Dilution | Reference |
---|---|
| |
image
image 1 :

Immunofluorescence analysis of methanol-fixed HeLa cells using PA5-21487 anti-Homer antibody at 1:500 dilution.
image 2 :
Immunohistochemical analysis of paraffin-embedded OVCA tissue using PA5-21487 anti-HOMER1 antibody at 1:100 dilution.
product information
Product Type :
Antibody
Product Name :
HOMER1 Polyclonal Antibody
Catalog # :
PA5-21487
Quantity :
100 µL
Price :
US 514
Clonality :
Polyclonal
Purity :
Antigen affinity chromatography
Host :
Rabbit
Reactivity :
Human, Mouse, Rat
Applications :
Immunocytochemistry: 1:100-1:1,000, Immunohistochemistry (Frozen): 1:100-1:1,000, Immunohistochemistry (Paraffin): 1:100-1:1,000, Immunoprecipitation: 1:100-1:500, Western Blot: 1:500-1:10,000
Species :
Human, Mouse, Rat
Isotype :
IgG
Storage :
Store at 4°C short term. For long term storage, store at -20°C, avoiding freeze/thaw cycles.
Description :
HOMER1 is a member of the homer family of dendritic proteins. Members of this family regulate group 1 metabotrophic glutamate receptor function.
Immunogen :
Recombinant fragment corresponding to a region within amino acids 72 and 339 of Homer (Uniprot ID#Q86YM7)
Format :
Liquid
Applications w/Dilutions :
Immunocytochemistry: 1:100-1:1,000, Immunohistochemistry (Frozen): 1:100-1:1,000, Immunohistochemistry (Paraffin): 1:100-1:1,000, Immunoprecipitation: 1:100-1:500, Western Blot: 1:500-1:10,000
Aliases :
HOMER; homer homolog 1; homer homolog 1 (Drosophila); homer protein homolog 1; homer scaffolding protein 1; homer, neuronal immediate early gene, 1; Homer1; homer-1; HOMER1A; HOMER1B; HOMER1C; HOMER1F; immediate early gene protein Homer1A; PSD-Zip45; scaffold protein; SYN47; VASP/Ena-related gene up-regulated during seizure and LTP 1; Ves-1; Vesl; Vesl1; Vesl-1
more info or order :
company information

Invitrogen
Thermo Fisher Scientific
81 Wyman Street
Waltham, MA USA 02451
https://www.thermofisher.com81 Wyman Street
Waltham, MA USA 02451
800-678-5599
headquarters: USA
related products
browse more products
questions and comments